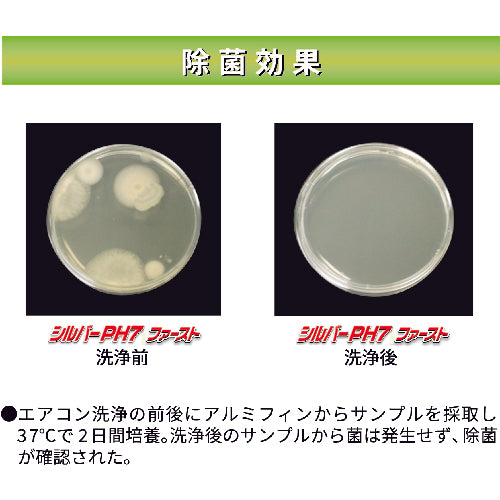

1
/
of
3
横浜油脂工業(株)
Linda Silver PH7 Fast 10kg NB57 1 piece
Linda Silver PH7 Fast 10kg NB57 1 piece
Regular price
¥7,392
Regular price
Sale price
¥7,392
Unit price
/
per
Shipping calculated at checkout.
Couldn't load pickup availability
Catalog number: NB57 Features: ●Does not damage aluminum fins and does not require neutralization after cleaning. ●Contains highly biodegradable surfactants. ●By cleaning air filters and heat exchangers, power consumption can be reduced by 20 to 40% and CO2 emissions can be reduced. Uses: ●For cleaning aluminum fins and filters. Specifications: ●Capacity (ml): 9900.9 ●Color: Colorless to pale yellow transparent ●Type: Neutral ●Dilution ratio: 10 times ●Height (mm): 235 ●Width (mm): 175 ●Capacity (kg): 10 ●Capacity (g): 10000 ●Capacity (L): 9.9 ●Neutral type Material/Finish: ●Main ingredients: Non-ionic surfactant, chelating agent, disinfectant, silver ion
View full details